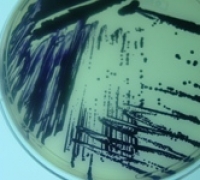

Quando bactérias patogênicas invadem o corpo humano ou de outros mamíferos, as células hospedeiras liberam substâncias tóxicas para tentar se livrar da presença indesejada. Uma nova pesquisa, feita na Universidade de São Paulo (USP), desvendou um dos mecanismos pelos quais certos tipos de bactérias se defendem desse ataque.
Os resultados, publicados este mês na PLoS One, abrem caminho para a descoberta de moléculas capazes de inibir o sistema de defesa bacteriano e dificultar o avanço da infecção.
A pesquisa, apoiada pela FAPESP, foi feita com a Chromobacterium violaceum, microrganismo que afeta principalmente o fígado e a pele de indivíduos com o sistema imunológico comprometido.
“A C. violaceum é uma bactéria oportunista. Pretendemos explorá-la como modelo para estudar patogenicidade porque ela já teve seu genoma sequenciado e é relativamente fácil manipulá-la geneticamente”, explicou Luis Eduardo Soares Netto, supervisor do estudo de pós-doutorado de José Freire da Silva Neto, que deu origem ao artigo.
Os cientistas investigaram o mecanismo de produção de uma enzima usada pela bactéria para decompor o peróxido orgânico, substância oxidante liberada pelas células hospedeiras após a invasão.
“O peróxido orgânico causa estresse oxidativo na bactéria, o que dificulta sua reprodução e pode levá-la à morte. Para se defender, o patógeno produz uma enzima antioxidante chamada Ohr. A produção dessa enzima, por sua vez, é regulada por outra proteína – que atua como fator de transcrição – chamada OhrR”, contou Netto.
Quando a bactéria está em condição basal, a proteína OhrR fica ligada ao gene responsável pela produção da enzima Ohr. “Dessa forma, impede que o DNA seja transcrito em RNA e que a enzima seja produzida”, disse.
Mas, ao entrar em contato com o peróxido orgânico, a OhrR se oxida e se desliga do DNA, permitindo a produção da enzima antioxidante. “Depois que a Ohr cumpre seu papel de decompor o peróxido orgânico, outra enzima chamada tiorredoxina entra em ação para fazer com que o fator de transcrição OhrR se ligue novamente ao gene e iniba a produção de Ohr”, explicou Netto.
Esse mecanismo de defesa também está presente em outros gêneros de bactérias, como Streptococcus e Pseudomonas – ambos causadores de doenças respiratórias, infecções cutâneas e sepse em humanos.
Também está presente em fitopatógenos como a Xylella fastidiosa, que causa nas laranjeiras a doença clorose variegada de citros, popularmente conhecida como praga do amarelinho.
Driblando a defesa
“Agora que sabemos como a bactéria se defende, podemos pensar em meios para driblar esse mecanismo. Uma possibilidade seria inibir a produção da enzima Ohr. Outra seria ativar a produção de OhrR, para anular o sistema antioxidante”, disse Netto.
O primeiro passo, segundo o pesquisador, seria demonstrar experimentalmente em camundongos que essas manobras genéticas realmente tornariam mais fácil para o organismo hospedeiro combater a bactéria.
Os testes ainda estão sendo padronizados, mas a ideia é silenciar os genes da Ohr e da OhrR na C. violaceum e avaliar se isso altera sua capacidade de infectar os animais.
“Como não existem homólogos da Ohr e da OhrR em mamíferos ou plantas, se conseguirmos desenhar uma molécula que atue sobre essas proteínas, ela teoricamente teria ação específica sobre a bactéria, sem efeito colateral para o hospedeiro”, afirmou Netto.
Embora ainda em fase preliminar, os estudos abrem caminho para o desenvolvimento de novos medicamentos. “Hoje já se sabe que muitos antibióticos têm como mecanismo de ação a geração de estresse oxidativo nas bactérias. Essa questão está ganhando força”, disse.
O estudo de pós-doutorado está vinculado ao Projeto Temático “Aspectos biológicos de tióis: estrutura proteica, defesa antioxidante, sinalização e estados redox” , coordenado por Netto. Também está ligado ao Instituto Nacional de Ciência e Tecnologia (INCT) de Processos Redox em Biomedicina (Redoxoma).